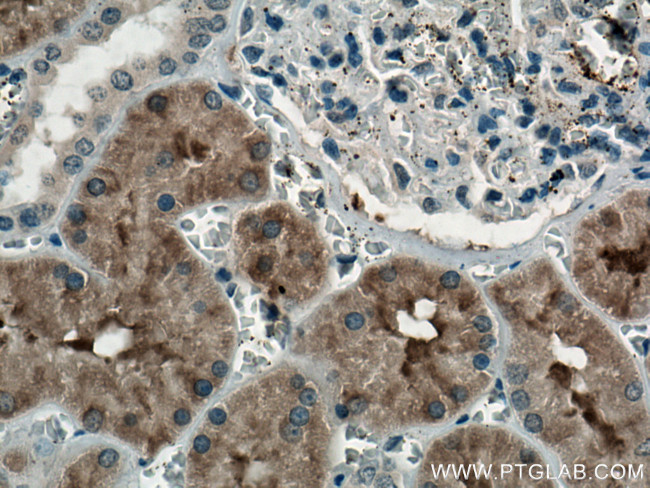
FTCD Antibody in Immunohistochemistry (Paraffin) (IHC (P))

Search
Proteintech
FTCD Monoclonal Antibody (1H8A1)
{{$productOrderCtrl.translations['antibody.pdp.commerceCard.promotion.promotions']}}
{{$productOrderCtrl.translations['antibody.pdp.commerceCard.promotion.viewpromo']}}
{{$productOrderCtrl.translations['antibody.pdp.commerceCard.promotion.promocode']}}: {{promo.promoCode}} {{promo.promoTitle}} {{promo.promoDescription}}. {{$productOrderCtrl.translations['antibody.pdp.commerceCard.promotion.learnmore']}}
产品信息
66979-1-IG
种属反应
宿主/亚型
分类
类型
克隆号
抗原
偶联物
形式
浓度
纯化类型
保存液
内含物
保存条件
运输条件
产品详细信息
Aliquoting is unnecessary for -20°C storage.
靶标信息
Golgi Protein, 58K is a bifunctional enzyme that channels 1-carbon units from formiminoglutamate, a metabolite of the histidine degradation pathway, to the folate pool. Mutations in this gene are associated with glutamate formiminotransferase deficiency. Alternatively spliced transcript variants have been found for this gene.
仅用于科研。不用于诊断过程。未经明确授权不得转售。
篇参考文献 (0)
生物信息学
蛋白别名: 58 kDa microtubule-binding protein; Formimidoyltransferase-cyclodeaminase; formiminotransferase cyclodeaminase; Formiminotransferase-cyclodeaminase; FTCD; glutamate formiminotransferase; LCHC1
基因别名: FTCD; LCHC1
UniProt ID: (Pig) P53603, (Human) O95954, (Mouse) Q91XD4, (Rat) O88618
Entrez Gene ID: (Pig) 397517, (Human) 10841, (Mouse) 14317, (Rat) 89833